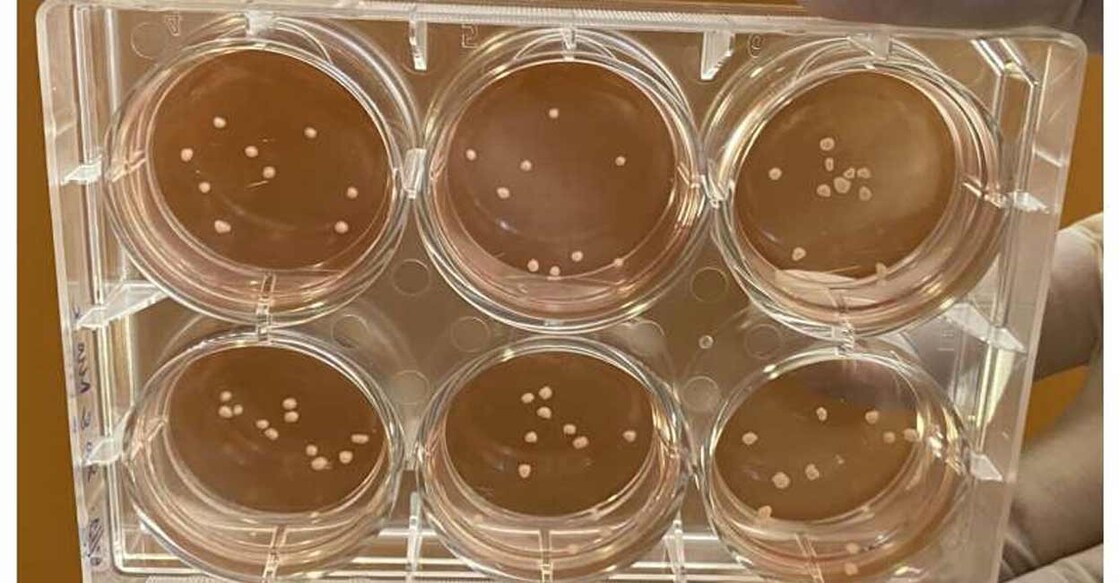
The organoids enable scientists to study how the human brain develops and communicates. Image courtesy: IANS

Researchers develop mini-brains in lab that mimic Parkinson's disease
Mail This Article
Singapore: A team of researchers here has for the first time grown tiny brains-in-a-dish that mimic the major pathological features of Parkinson's disease -- a common age-related neurodegenerative disorder.
The research, led by scientists from the Genome Institute of Singapore (GIS), the National Neuroscience Institute (NNI) and Duke-NUS Medical School, published in the Annals of Neurology, offers a new way to study how the degenerative brain disease progresses and explore possible new treatments.
The team grew the small pea-sized human midbrain-like organoids from human stem cells into a bundle of neurons and other cells found in the brain. The organoids enable scientists to study how the human brain develops and communicates.
They are essentially three-dimensional, multicellular, in vitro tissue constructs that mimic the human midbrain.
"These experiments are the first to recreate the distinctive features of Parkinson's disease that we see only in human patients," said Hyunsoo Shawn Je, Associate Professor, from the Neuroscience and Behavioural Disorders Programme at Duke-NUS.
"We have created a new model of the pathology involved, which will allow us to track how the disease develops and how it might be slowed down or stopped," Je added.
By manipulating the DNA of the starting stem cells to match genetic risk factors found in patients with Parkinson's disease, the study scientists were able to grow organoids with neurons that showed both Lewy bodies and the progressive loss of dopamine-producing neurons.
The organoid system will enable research into Parkinson's disease and other conditions not possible with current animal models. The team is already using organoids to investigate why and how Lewy bodies form in human brain cells, and screen drugs that can potentially stop disease progression.
"This discovery provides insights and a 'humanised' disease model that can facilitate drug testing against Parkinson's disease and dementia. Our organoid model with a genetic mutation on the GBA gene is also highly relevant as we have several of these genetic mutation carriers locally," said Professor Tan Eng King, Deputy Medical Director, at NNI.

